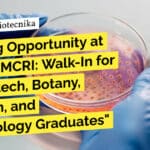
Exciting Opportunity at CSIR-CSMCRI: Walk-In for BSc Biotech, Botany, Biochem, and Microbiology Graduates "Exciting Opportunity at CSIR-CSMCRI: Walk-In for BSc Biotech, Botany, Biochem, and Microbiology Graduates"
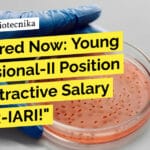
Get Hired Now: Microbiology Position with Attractive Salary at ICAR-IARI! ICAR-IARI Molecular Biology Young Professional Job - Apply Now

Home Search
biology - search results
If you're not happy with the results, please do another search
Government CLRI Biology & Biochemistry Project Vacancies – Apply Now and Secure Your Future!
Government CLRI Biology & Biochemistry Project Vacancies - Apply Now and Secure Your Future!
CSIR – CENTRAL LEATHER RESEARCH INSTITUTE
Council of Scientific & Industrial Research
Adyar,...
CSIR-CSMCRI Project Recruitment Biotech & Microbiology, Attend Walk-In
CSMCRI Project Recruitment Biotech & Microbiology, Attend Walk-in
Walk-in-interview on 12 February 2024
The Division of Plant Omics at CSIR-CSMCRI, Bhavnagar is actively engaged in multidisciplinary research in...
Licious Microbiology Lab Technologist Job – BSc & MSc Microbiology Apply
Licious Microbiology Lab Technologist Job - BSc & MSc Microbiology Apply
Lab Technologist
Location: Delhi
Employment Type: On-site Full-time Associate
About the job
Who are we?
We are Licious and...
Exciting Opportunity at CSIR-CSMCRI: Walk-In for BSc Biotech, Botany, Biochem, and Microbiology Graduates
CSIR-CSMCRI BSc Biotech, Botany, Biochem & Microbiology - Attend Walk-In
Walk-in- Interview on 02.02.2024
Project: “Development of seaweed-based larvicide for control of mosquito vectors of VBDs (Two...
INST Mohali Microbiology Project Job – Life Sciences Apply
INST Mohali Microbiology Project Job - Life Sciences Apply
INSTITUTE OF NANO SCIENCE & TECHNOLOGY
(An Autonomous Research Institute of the Department of Science and Technology,...
Exciting Job Opportunity in Microbiology & Life Sciences! Apply Now at JNU, Delhi
JNU Project Vacancy Available - MSc Microbiology & Life Sciences Apply
School of Life Sciences
Jawaharlal Nehru University
New Delhi – 110067
Advertisement for Project Associate-II, Position -(1)
Application...
Get Hired Now: Microbiology Position with Attractive Salary at ICAR-IARI!
ICAR-IARI Molecular Biology Young Professional Job - Apply Now
Division of Microbiology
ICAR INDIAN AGRICULTURAL RESEARCH INSTITUTE
NEW DELHI-110012
Walk-in interview
Applications are invited for the post of Young...
Life Sciences, Biochem, Microbiology & Biotech Research Job Available! Walk-In Today at ICMR-NICPR!
ICMR-NICPR BTech Biotech - BSc, MSc Life Sciences Attend Walk-In
ICMR- National Institute of Cancer Prevention and Research
Indian Council of Medical Research (Department of Health...
PepsiCo SC QC Job For Food Tech & Microbiology Candidates, Apply Online
PepsiCo SC QC Job For Food Tech & Microbiology Candidates, Apply Online
Assistant Manager - SC Quality Control
Pune, India
Supply Chain
256050
Yes -...
Exciting Job Opportunity as a Senior Research Associate – Assay Biology at Syngene Amgen...
Syngene R&D Job Opening - Biotech & Biological Sciences Apply
Senior Research Associate – Assay Biology
Syngene (www.syngeneintl.com) is an innovation-led contract research, development and manufacturing...
Walk-In Interview for Microbiology Job at Torrent Pharmaceuticals Ltd – BSc & MSc Graduates...
Torrent Pharmaceuticals Ltd Microbiology Executive Job - BSc & MSc Attend Walk-In
Job Posting: Technical Assistant / Executive - Microbiology
Torrent Pharmaceuticals Ltd is a leading...
PhD Freshers Wanted for Sun Pharma R&D Job – Biotech, Biochem, Microbiology & Mol...
PhD Freshers Sun Pharma R&D Job For Biotech, Biochem, Mol Bio
About the Company
Sun Pharma is a leading pharmaceutical company committed to the development and...
Exciting Project Jobs in Biology and Biotechnology at CSIR-Innovation Protection Unit – Apply Now!
CSIR-Innovation Protection Unit BSc Biology, Biotechnology Project Jobs - Applications Invited
CSIR-Innovation Protection Unit
3rd Floor, Vigyan Suchana Bhavan
14, Satsang Vihar Marg, New Delhi – 110...
DIAGEO Quality Executive Opportunity – Biotech, Biochem & Microbiology Apply Online
DIAGEO Quality Executive Opportunity - Biotech, Biochem & Microbiology Apply Online
At DIAGEO, we are a global leader in alcoholic beverages, committed to producing quality...
Annapurna QA Job Opening – MSc Food Tech, Microbiology Apply
Annapurna QA Job Opening - MSc Food Tech, Microbiology Apply
Quality Assurance Manager
About the job
Annapurna Group is looking for Asst. Manager - Quality Assurance &...